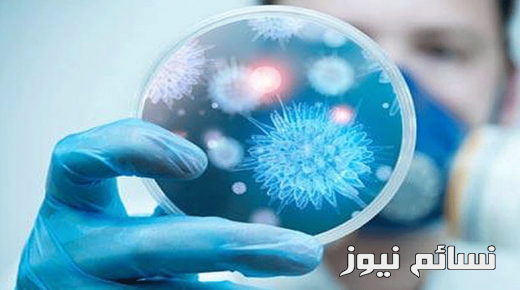
فيروس “كورونا” يتسبب في توقيف سعودي وحفيدته في هونج كونج .. والصحة تطمئن في الجوف

أكاديمية سعودية تتهم جامعة الجوف بفصلها تعسفيا والمتحدث باسم الجامعة يرد ويكشف الحقائق
قامت أكاديمية سعودية بإتهام جامعة الجوف بفصلها بشكل تعسفي بعد أن عُيّنت لمدة خمس أشهر فقط وطالبت بإعادتها للوظيفة...
خطيبته متورطة .. كشف رموز جريمة إختطاف مواطن في الطائف وتصويره عاريا
تمكن مركز شرطة القريع بني مالك الذي يتبع شرطة محافظة نيسان جنوب الطائف من فك رموز الجريمة التي طالت...
لعبة مريم : بالفيديو .. ماذا قال مطور اللعبة ؟ وماذا رد على الإنتقادات الموجهة له ؟
لعبة مريم ، قال المبرمج المعتمد في بحوث الذكاء الإصطناعي والإنترنت سليمان الحربي والذي قام بتطوير لعبة مريم التي...
تعرف على عدد المسقطين من مستفيدي الضمان الإجتماعي والأسباب كاملة
قامت وزارة العمل والتنمية الإجتماعية في المملكة العربية السعودية بإسقاط حوالي 440 ألف مستفيد من الضمان الإجتماعي للسنة الماضية...
فيروس “كورونا” يتسبب في توقيف سعودي وحفيدته في هونج كونج .. والصحة تطمئن في الجوف
ذكرت وسائل إعلام في هونج كونج أن المسؤولين في وزارة الصحة قاموا بإيقاف مواطن سعودي مع حفيدته في إحدى...
إضبط تردد قناة ام بي سي برو سبورت MBC PRO SPORTS الجديد لمتابعة مباريات دوري جميل على عرب سات .. شرح بالفيديو
تردد قناة ام بي سي برو سبورت ، مع عودة دوري جميل من جديد للمنافسات يوم أمس بدأت قنوات...
نتيجة مباراة الشباب وأحد اليوم وملخص أهداف سقوط الليث الشبابي على ملعب استاد الأمير فيصل بن فهد
نتيجة مباراة الشباب وأحد اليوم ، يستضيف نادي الشباب فريق أحد ضمن الأسبوع الأول من دوري جميل السعودي للمحترفين 1438...
جدول ترتيب الدوري السعودي 2017 / 2018 بعد إفتتاح الجولة الاولى من دوري جميل وترتيب الهدافين حتى الآن
جدول ترتيب الدوري السعودي ، إفتتحت مباريات دوري جميل السعودي للمحترفين 2017 / 2018 لكرة القدم من خلال مبارتين يوم...
نتيجة مباراة النصر والفيصلي اليوم وملخص أهداف العالمي أمام عنابي سدير دوري جميل الجولة الأولى
نتيجة مباراة النصر والفيصلي اليوم ، على ملعب استاد مدينة الملك سلمان بن عبدالعزيز الرياضية يستضيف نادي الفيصلي السعودي نظيره...